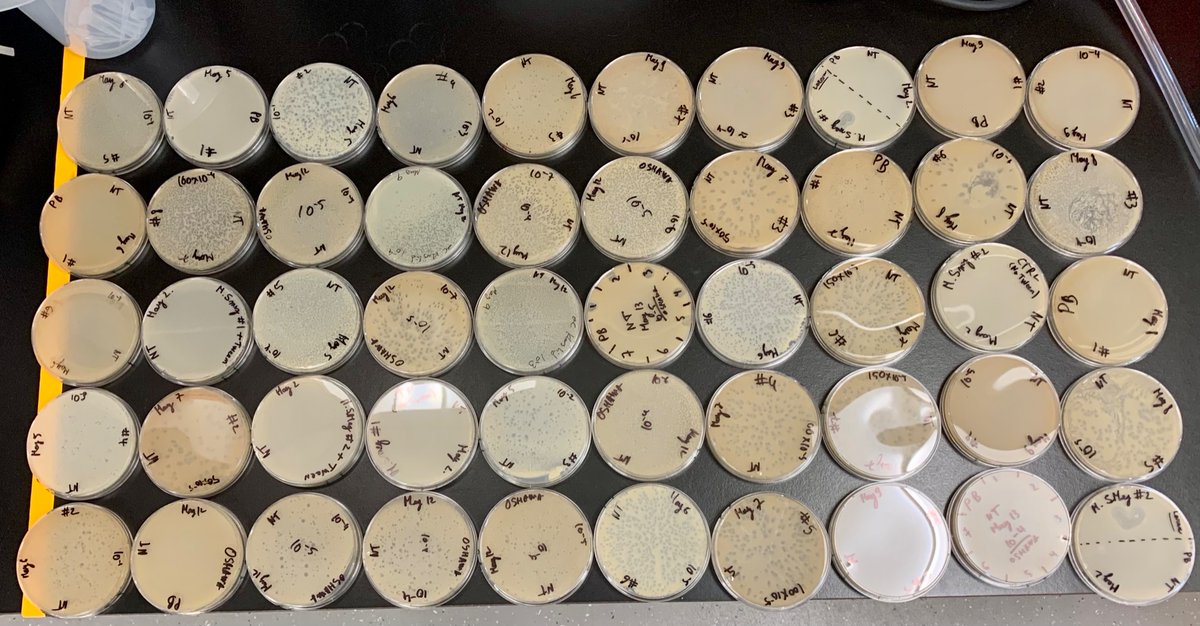
Nicolas Toex tweet media

Nicolas Toex retweetledi
Nicolas Toex
22 posts

Nicolas Toex
@NicolasToex
Maastricht University BaMed 🩺 🇳🇱| uOttawa https://t.co/HfeGgE2T68 + https://t.co/LhI6ypCdj9 🇨🇦 | Phage Enthusiast
Maastricht, The Netherlands Katılım Ağustos 2014
144 Takip Edilen54 Takipçiler

Nicolas Toex retweetledi

@meharper_ottawa and @DowneyUOttawa with the Winners of the inaugural OISB-NRC Graduate Student Fellowships - Extending our Collaborative Agreement with @NRC_CNRC HHT and DT divisions ! Congrats to All!

English
Nicolas Toex retweetledi

That's the reason I love #electronmicroscopy
You can see cool stuff like this :D
Any ideas what's going on here?

English
Nicolas Toex retweetledi

We are thrilled to announce that the registration for the 6th Luxembourg Microbiology Day is now open! May 11th at @LNS_Lux. More details and registration form are here 👉 microbiology.lu/lsfm-day-2023/. We hope to see you there! 🦠🔬😃 🇱🇺

English

I ranked #2 on the Whova leaderboard at SEA Symposium 2023! - via #Whova event app #hhmi #seaphages #seagenes #uottawaphagehunters #hhmisea
Representing🇨🇦@uOttawaMed @uOttawaTMM
Join us April 14th-16th!

English
Nicolas Toex retweetledi

VCRT: Student first-responders are here for all your medical emergencies
.
.
ow.ly/xzp450NcfZm
English

Last day before the Relay for Life at uOttawa! Make a difference in the research for Cancer here! #RelayforLife #uOttawa #research
support.cancer.ca/site/TR/RelayF…
Ottawa, Ontario 🇨🇦 English
Nicolas Toex retweetledi

We are excited to have Virgis Siksnys as our keynote speaker as well as an amazing group of invited speakers for #CRISPR2023! Details of most of the invited speakers for #CRISPR2023 are available on our website.
crispr2023.info/speakers/
English

Here is an #accessible version of our #capsule!
#Science #Canada #uOttawa #Plaque #Education #uOttawaTMM #uOttawaBMI #Research #AMPK #HMGCR
Ottawa, Ontario 🇨🇦 English

Hey Twitter!
Don’t miss on our interview of @Immunometabolab about his recent #advances in the field of #Atherosclerosis!
#listen: bit.ly/3VRydSO
@EmilioIAlarcon1, @uOttawaTMM, @uOttawaBMI,
@uOttawaMed, @INTBIOTECH_CAN, and
@BEaTSResearch
#Immunometabolism #SciComm

Ottawa, Ontario 🇨🇦 English

@BaptisteLacost3 @uOttawaTMM @AtElectron Oops, yes! Need to give also credit to @AtElectron for letting us use the TEM! Thanks @BaptisteLacost3 🙂
English

Imaging some of the students phages today! Found some interesting groups of them here!
#TEM #phages #PhageHunters @uOttawaTMM


English
Nicolas Toex retweetledi
Nicolas Toex retweetledi

Vous voulez savoir comment vendre aux hôpitaux ? Rejoignez-nous le 25 octobre pour comprendre comment une découverte en laboratoire devient un médicament, un dispositif ou une application mobile pour aider les patients !
🔗eventbrite.ca/e/bench-biz-be…

Français
Nicolas Toex retweetledi

📸
#ScienceExposed Top 20 is back!
[Microglial cells monitoring the brain]
by @NicolasToex & @BaptisteLacost3,
@uOttawa & @uOttawaBMRI.
To vote for this image for the 2022 People’s Choice Award 🏆, click here ▶️ tinyurl.com/3uzktese

English
Nicolas Toex retweetledi

Thank you @PhageCanada for the awesome and well-organized symposium. And congratulations to Enzhe Galimova, my lab colleague in the Rudner’s lab, for winning the undergraduate best talk award👏

English
Nicolas Toex retweetledi

5 jour pour postuler ! Appel aux étudiant(e)s de 3e et 4e année en @uOttawaArts, @uOttawaGenie, @uOttawaMed, @uOttawaScience et @Telfer_uOttawa ! 📣
Notre équipe recrute des étudiant(e)s ambassadeur(e)s pour l'année universitaire 2022/23 ! 🎒
bit.ly/3b8IZCw

Français